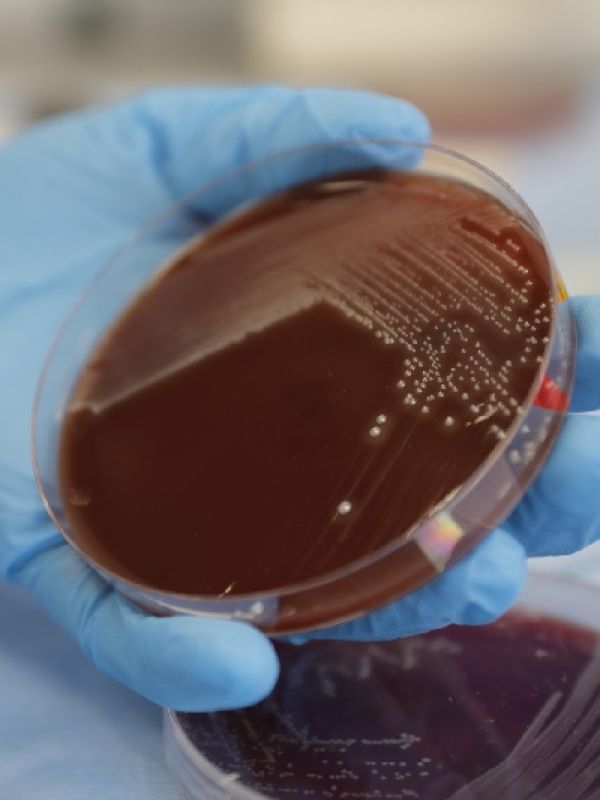

DOCTORADO EN CIENCIAS NATURALES
¿Quieres recibir más información?

DESCRIPCIÓN DEL PROGRAMA
El Doctorado en Ciencias Naturales forma, desde una visión amplia de las ciencias naturales, investigadores capaces de plantear y desarrollar propuestas construidas sobre fundamentos teóricos sólidos, y preguntas y estrategias pertinentes para la resolución de necesidades locales, regionales y globales. El proceso formativo incluye la fundamentación teórica con un mínimo de asignaturas obligatorias con amplia flexibilidad y un énfasis mayoritario en el desarrollo de competencias y habilidades prácticas en investigación. El doctorado integra múltiples visiones producto de la diversidad del cuerpo docente, siendo atractivo para investigadores en formación de múltiples carreras afines a las ciencias naturales.
- Código SNIES: 110215
- Valor del semestre: $ 18.780.000
- 90 créditos académicos
- Nombre del programa: Doctorado en Ciencias Naturales
- Nivel de formación: Doctorado
- Modalidad del programa: Presencial
- Título otorgado: Doctor(a) en Ciencias Naturales
- Lugar de ofrecimiento: Bogotá D.C. - Sede Quinta de Mutis
- Horario: Tiempo completo
- Periodicidad de admisión: Anual
- Número de resolución con fecha de vigencia: 008260 del 18 de mayo de 2021
- Duración: 8 semestres
¿Por qué estudiar Doctorado en Ciencias Naturales?
PLAN DE ESTUDIOS
El doctorado se desarrolla en 8 semestres y tiene dos ciclos de formación, a saber:
i. Fundamentación teórica y metodológica: busca el fortalecimiento de los saberes básicos y profesionalizantes propios de las ciencias naturales.
ii. Investigación (proyecto de tesis, tesis y pasantía): busca el fortalecimiento de capacidades para la investigación autónoma reconociendo en las habilidades para desarrollar un proyecto de investigación el eje de la formación doctoral.
Las asignaturas electivas en 2025-2 serán:
- Hidrología
- Geología de Colombia
- Oceanografía
- Genética Evolutiva
- Pensamiento Crítico y Diseño Experimental en Ecología
- Biología Molecular
- Parasitología
- Introducción a la Manipulación y Análisis de Datos en R
- Ecología Cognitiva
- Ecología de Mamíferos Marinos
- Urban Ecology and Evolution

Profesores
- Su formación constituye uno de nuestros sellos diferenciales: la interdisciplinariedad.
- Son profesionales expertos en cada una de sus áreas del conocimiento, con experiencia investigativa y docente.
- Cuentan con competencias en investigación, extensión y consultoría, en el sector público y privado, con reconocimiento nacional e internacional.
- Cuentan con un amplio record de publicaciones científicas internacionales, y una extensa red de colaboración internacional.
- Cuentan con experiencia en dirección de tesis de pregrado, maestría y doctorado" en áreas de Ciencias Biológicas y áreas de Ciencias del Sistema Tierra.


PERFIL
del egresado
Espacios de aprendizaje
La Facultad de Ciencias Naturales cuenta con espacios exclusivos de investigación dotados con equipos diversos para desarrollar investigación en múltiples áreas, que es el espacio natural de trabajo de los doctorandos. Además, los estudiantes doctorales cuentan con puestos de trabajo dotados con equipos de cómputo, de acuerdo con su dedicación exclusiva de tiempo completo.
Proceso de Admisión

LO QUE DEBES SABER
CONOCE LOS REQUISITOS PARA EMPEZAR A HACER DE TUS PASIONES UN SUEÑO HECHO REALIDAD